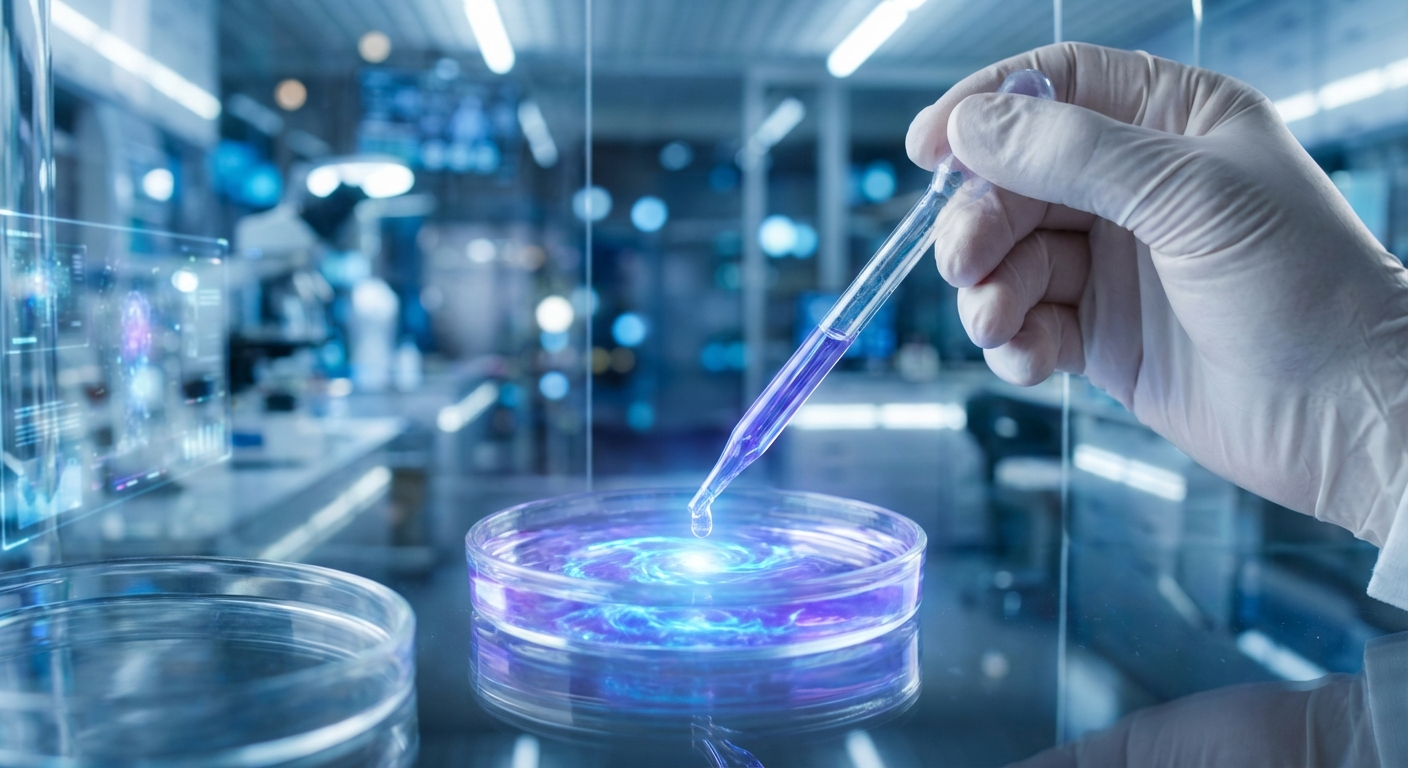
美姿颜科研实验室

关于美姿颜
美姿颜生物科技有限公司成立于21世纪初,总部位于中国化妆品产业高地。我们拥有一流的研发团队和符合国际标准的GMP生产车间,专注于生物活性成分的提取与应用。
作为化妆品行业的创新引领者,我们不仅提供高品质的产品,更致力于推动行业的可持续发展与技术进步。美姿颜,让美更有深度。

产品中心
精研配方,定义色彩与质感的极致体验

纤长浓密睫毛膏
极细刷头,精准捕捉每一根睫毛,打造根根分明的浓密效果。

水光玻璃唇釉
晶莹剔透,赋予双唇灵动水光感,长效滋润不粘腻。

丝绒哑光口红
浓郁显色,丝绒质地,一抹即刻拥有高级质感红唇。

立体闪耀高光
细腻粉质,如星光般闪耀,轻松打造立体通透的轮廓。

柔焦持妆粉饼
一秒磨皮,长效控油,呈现无暇柔焦雾面妆感。

元气柔雾腮红
自然显色,轻薄贴肤,由内而外透出自然好气色。
智造工厂 & OEM/ODM
美姿颜拥有超过20,000平方米的现代化生产基地,配备国际领先的自动化生产线。我们提供从配方研发、包装设计到成品生产的一站式 OEM/ODM 服务。
- 10万级洁净车间
- ISO 22716 & GMPC 认证
- 日产能力:睫毛膏 50,000支 / 唇彩 80,000支
- 全球供应链资源整合

科研创新
在美姿颜,创新是我们发展的核心动力。我们每年的研发投入占营收的10%以上,与全球多家知名科研机构建立了深度合作关系。
从基础研究到配方开发,从安全性评估到功效验证,我们严谨对待每一个环节,确保每一款产品都能经受住科学的检验。
联系我们
期待与您的深度合作
美姿颜生物科技有限公司
地址: 浙江金华浦江文创路336号
电话: 13867919199
邮箱: 13867919199@163.com
商务洽谈: 13867919199@163.com
